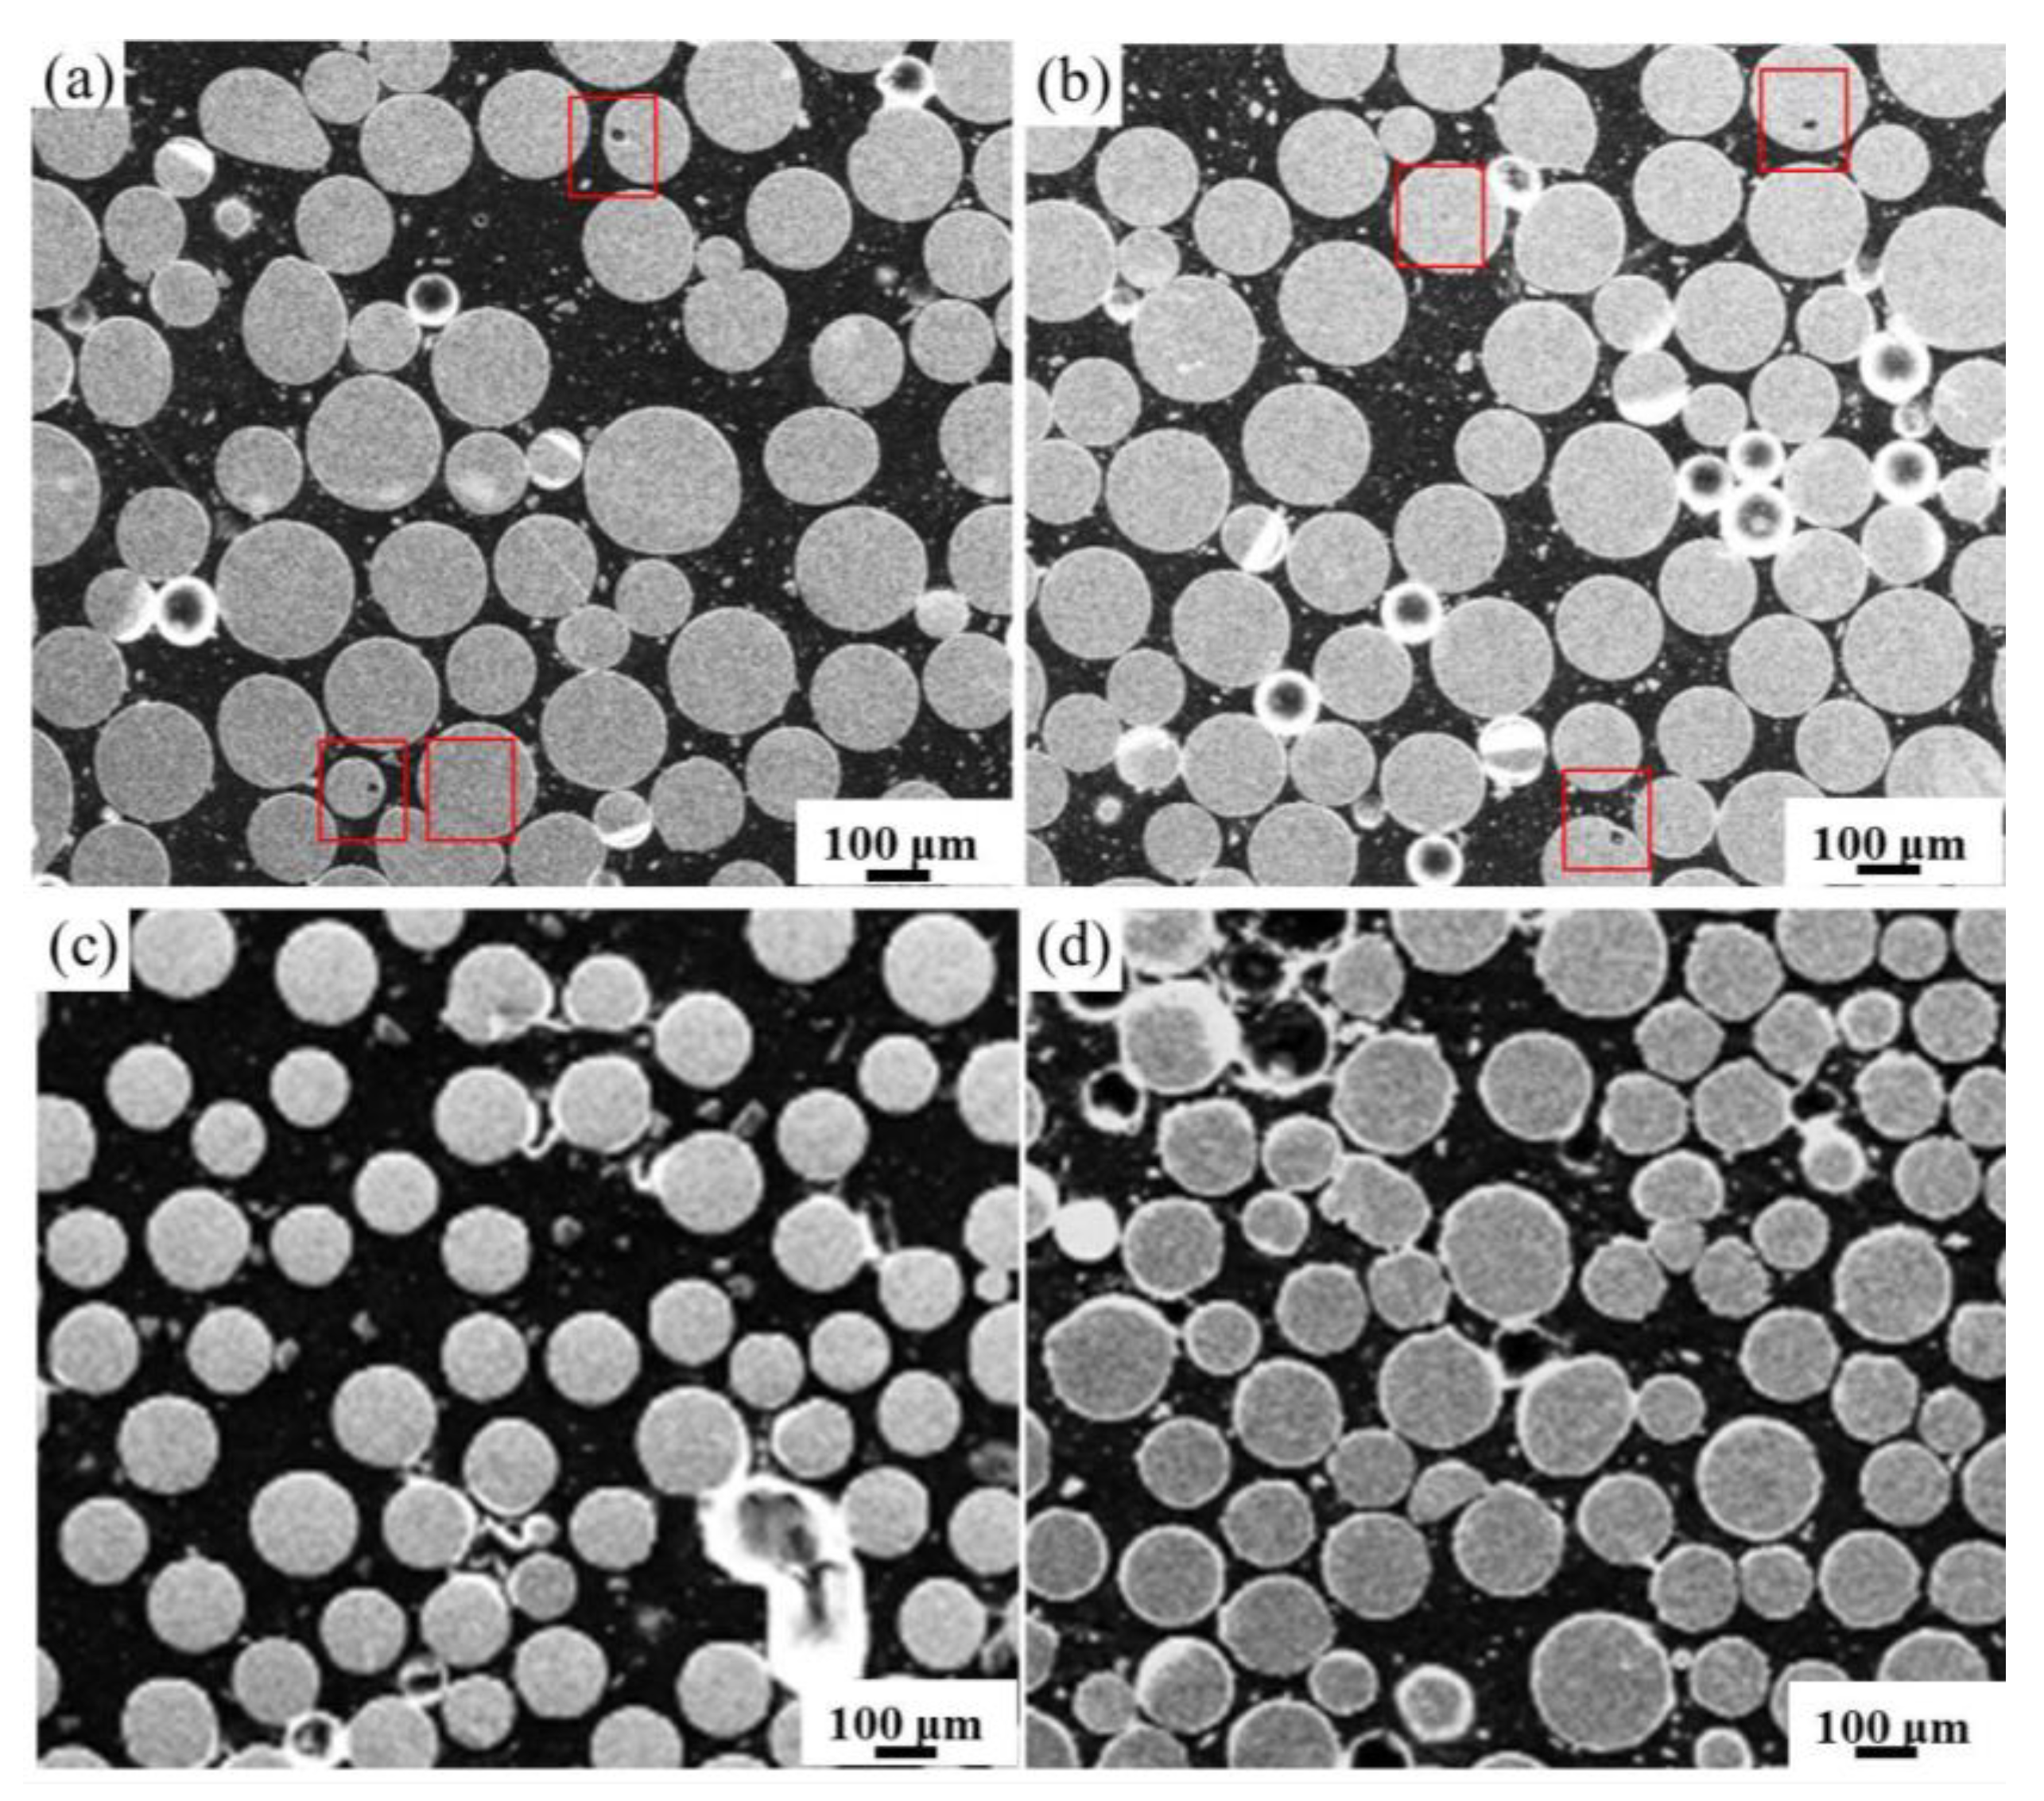
Materials 14 01177 g001 Materials 14 01177 g001

A Study on Internal Defects of PREP Metallic Powders by Using X-ray Computed Tomography
Abstract
1. Introduction
2. Experimental
3. Results
4. Discussion
4.1. Effect of Particle Size on Pore Characteristics
4.2. Effect of Rotation Speed and Alloy Type on Pore Characteristics
5. Conclusions
- For a given alloy, pores are more likely to form in coarse particles, and the volume of pores increases with increasing particle size.
- For a given alloy, the quantity percentage of powder with pores in the as-PREPed powder increases gradually with decreasing rotation speed.
- The surface tension() and density() of alloy play a key role in pore characteristics. The alloys with high / have a large average particle size, which may cause more powders with pores. In addition, alloys with low surface tension are more likely to absorb argon. The quantity percentage of powder with pores in Ti-6Al-4V is the largest among three alloys.
Author Contributions
Funding
Institutional Review Board Statement
Informed Consent Statement
Data Availability Statement
Conflicts of Interest
References
- Gibson, I.; Rosen, D.W.; Stucker, B. Additive Manufacturing Technologies; Springer: New York, NY, USA, 2010. [Google Scholar]
- Herzog, D.; Seyda, V.; Wycisk, E.; Emmelmann, C. Additive manufacturing of metals. Acta Mater. 2016, 117, 371–392. [Google Scholar] [CrossRef]
- Frazier, W.E. Metal additive manufacturing: A review. J. Mater. Eng. Perform. 2014, 23, 1917–1928. [Google Scholar] [CrossRef]
- Cunningham, R.; Narra, S.P.; Montgomery, C.; Beuth, J.; Rollett, A.D. Synchrotron-based X-ray microtomography characterization of the effect of processing variables on porosity formation in laser power-bed additive manufacturing of Ti-6Al-4V. JOM 2017, 69, 479–484. [Google Scholar] [CrossRef]
- Cunningham, R.; Nicolas, A.; Madsen, J.; Fodran, E.; Anagnostou, E.; Sangid, M.D.; Rollett, A.D. Analyzing the effects of powder and post-processing on porosity and properties of electron beam melted Ti-6Al-4V. Mater. Res. Lett. 2017, 5, 516–525. [Google Scholar] [CrossRef]
- Chen, G.; Zhao, S.Y.; Tan, P.; Wang, J.; Xiang, C.S.; Tang, H.P. A comparative study of Ti-6Al-4V powders for additive manufacturing by gas atomization, plasma rotating electrode process and plasma atomization. Powder Technol. 2018, 333, 38–46. [Google Scholar] [CrossRef]
- Chen, G.; Zhou, Q.; Zhao, S.Y.; Yin, J.O.; Tan, P.; Li, Z.F.; Ge, Y.; Wang, J.; Tang, H.P. A pore morphological study of gas-atomized Ti-6Al-4V powders by scanning electron microscopy and synchrotron X-ray computed tomography. Powder Technol. 2018, 330, 425–430. [Google Scholar] [CrossRef]
- Brooks, A.J.; Ge, J.H.; Kirka, M.M.; Dehoff, R.R.; Bilheux, H.Z.; Kardjilov, N.; Manke, I.; Butler, L.G. Porosity detection in electron beam-melted Ti-6Al-4V using high-resolution neutron Imaging and grating-based interferometry. Prog. Addit. Manuf. 2017, 2, 125–132. [Google Scholar] [CrossRef]
- Zhang, F.; Gao, Z.J.; Teng, M. Metal powder materials for additive manufacturing and their preparation Methods. Ind. Technol. Innov. 2017, 4, 59–63. [Google Scholar]
- Tang, J.J.; Nie, Y.; Li, Q.; Li, Y.P. Characteristics and atomization behavior of Ti-6Al-4V powder produced by plasma rotating electrode process. Adv. Powder Technol. 2019, 30, 2330–2337. [Google Scholar] [CrossRef]
- Chen, S.Q.; Huang, B.Y. Status and development of gas atomization for preparation of metal powders. J. Ind. Ecol. 2003, 6, 13–26. [Google Scholar]
- Susan, D.F.; Puskar, J.D.; Brooks, J.A.; Robino, C.V. Quantitative characterization of porosity in stainless steel LENS powders and deposits. Mater. Charact. 2006, 57, 36–43. [Google Scholar] [CrossRef]
- Zhang, Y.W. Investigation of Porosity in Superalloy Powder. J. Iron Steel Res. 2002, 14, 73–76. [Google Scholar]
- Gerling, R.; Leitgeb, R.; Schimansky, F.P. Porosity and argon concentration in gas atomized γ-TiAl powder and hot isostatically pressed compacts. Mater. Sci. Eng. A 1998, 252, 239–247. [Google Scholar] [CrossRef]
- Rabin, B.H.; Smolik, G.R.; Korth, G.E. Characterization of entrapped gases in rapidly solidified powders. Mater. Sci. Eng. A 1990, 124, 1–7. [Google Scholar] [CrossRef]
- Wegmann, G.; Gerling, R.; Schimansky, F.P. Temperature induced porosity in hot isostatically pressed gamma titanium aluminide alloy powders. Acta Mater. 2003, 51, 741–752. [Google Scholar] [CrossRef]
- Williams, S.T.; Withers, P.J.; Todd, I. The effectiveness of hot-isostatic pressing for closing porosity in titanium parts manufactured by selective electron beam melting. Metall. Mater. Trans. A 2016, 47, 1939–1946. [Google Scholar] [CrossRef]
- Ahsan, M.N.; Pinkerton, A.J.; Moat, R.J. A comparative study of laser direct metal deposition characteristics using gas and plasma-atomized Ti–6Al–4V powders. Mater. Sci. Eng. A 2011, 528, 7648–7657. [Google Scholar] [CrossRef]
- Chen, G.; Tan, P.; Zhao, S.Y.; He, W.W.; Tang, H.P. Spherical Ti-6Al-4V powders produced by gas atomization. Key Eng. Mater. 2016, 704, 287–292. [Google Scholar] [CrossRef]
- Sun, P.; Fang, Z.Z.; Zhang, Y.; Xia, Y. Review of the methods for production of spherical Ti and Ti alloy powder. JOM 2017, 69, 1853–1860. [Google Scholar] [CrossRef]
- Liss, K.D.; Bartels, A.; Schreyer, A. High-energy X-rays: A tool for advanced bulk investigations in materials science and physics. Texture. Microstruct. 2003, 35, 219–252. [Google Scholar] [CrossRef]
- Williams, S.T.; Zhao, H.; Léonard, F.; Derguti, F.; Todd, I.; Prangnell, P.B. XCT analysis of the influence of melt strategies on defect population in Ti-6Al-4V components manufactured by selective electron beam melting. Mater. Charact. 2015, 102, 47–61. [Google Scholar] [CrossRef]
- Ziółkowski, G.; Chlebus, E.; Szymczyk, P. Application of X-ray CT method for discontinuity and porosity detection in 316Lstainless steel parts produced with SLM technology. Arch. Civ. Mech. Eng. 2014, 14, 608–614. [Google Scholar] [CrossRef]
- Kim, F.H.; Moylan, S.P.; Garboczi, E.J.; Slotwinski, J.A. Investigation of pore structure in cobalt chrome additively manufactured parts using X-ray computed tomography and three-dimensional image analysis. Addit. Manuf. 2017, 17, 23–38. [Google Scholar] [CrossRef] [PubMed]
- Nie, Y.; Tang, J.J.; Teng, J.W.; Ye, X.J.; Yang, B.B.; Huang, J.F.; Yu, S.; Li, Y.P. Particle defects and related properties of metallic powders produced by plasma rotating electrode process. Adv. Powder Technol. 2020, 31, 2912–2920. [Google Scholar] [CrossRef]
- Cai, X.Z.; Eylon, D. Features of the solidified microstructure of PREP TiAl base alloy powders. Rare Met. Mater. Eng. 1994, 23, 41–47. [Google Scholar]
- He, W.; Liu, Y.; Tang, H.; Li, Y.P.; Liu, B.; Liang, X.P.; Xi, Z.P. Microstructural characteristics and densification behavior of high-Nb TiAl powder produced by plasma rotating electrode process. Mater. Des. 2017, 132, 275–282. [Google Scholar] [CrossRef]
- Guo, R.P.; Xu, L.; Zong, Y.P. Characterization of prealloyed Ti–6Al–4V powders from EIGA and PREP process and mechanical properties of HIPed powder compacts. Acta Metall. Sin. 2017, 30, 1–10. [Google Scholar] [CrossRef]
- Frost, A.R. Rotary atomization in the ligament formation mode. J. Agric. Eng. Res. 1981, 26, 63–78. [Google Scholar] [CrossRef]

Publisher’s Note: MDPI stays neutral with regard to jurisdictional claims in published maps and institutional affiliations. |
© 2021 by the authors. Licensee MDPI, Basel, Switzerland. This article is an open access article distributed under the terms and conditions of the Creative Commons Attribution (CC BY) license (http://creativecommons.org/licenses/by/4.0/).
Share and Cite
Nie, Y.; Tang, J.; Huang, J.; Yu, S.; Li, Y. A Study on Internal Defects of PREP Metallic Powders by Using X-ray Computed Tomography. Materials 2021, 14, 1177. https://doi.org/10.3390/ma14051177
Nie Y, Tang J, Huang J, Yu S, Li Y. A Study on Internal Defects of PREP Metallic Powders by Using X-ray Computed Tomography. Materials. 2021; 14(5):1177. https://doi.org/10.3390/ma14051177
Chicago/Turabian StyleNie, Yan, Junjie Tang, Junfei Huang, Shu Yu, and Yunping Li. 2021. "A Study on Internal Defects of PREP Metallic Powders by Using X-ray Computed Tomography" Materials 14, no. 5: 1177. https://doi.org/10.3390/ma14051177
APA StyleNie, Y., Tang, J., Huang, J., Yu, S., & Li, Y. (2021). A Study on Internal Defects of PREP Metallic Powders by Using X-ray Computed Tomography. Materials, 14(5), 1177. https://doi.org/10.3390/ma14051177
